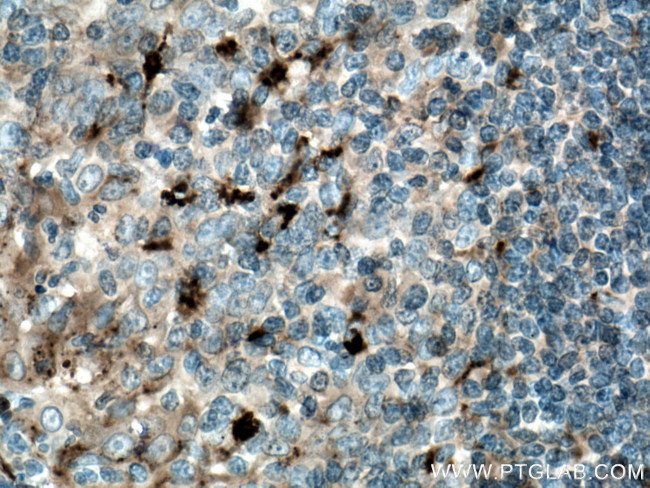
alpha 1 Antichymotrypsin Antibody in Immunohistochemistry (Paraffin) (IHC (P))

Search
Proteintech
alpha 1 Antichymotrypsin Monoclonal Antibody (3F2F10)
{{$productOrderCtrl.translations['antibody.pdp.commerceCard.promotion.promotions']}}
{{$productOrderCtrl.translations['antibody.pdp.commerceCard.promotion.viewpromo']}}
{{$productOrderCtrl.translations['antibody.pdp.commerceCard.promotion.promocode']}}: {{promo.promoCode}} {{promo.promoTitle}} {{promo.promoDescription}}. {{$productOrderCtrl.translations['antibody.pdp.commerceCard.promotion.learnmore']}}
产品信息
66078-1-IG
宿主/亚型
分类
类型
克隆号
抗原
偶联物
形式
浓度
规格
保存条件
运输条件
产品详细信息
Immunogen sequence: DKNVIFSPL SISTALAFLS LGAHNTTLTE ILKGLKFNLT ETSEAEIHQS FQHLLRTLNQ SSDELQLSMG NAMFVKEQLS LLDRFTEDAK RLYGSEAFAT DFQDSAAAKK LINDYVKNGT RGKITDLIKD LDSQTMMVLV NYIFFKAKWE MPFDPQDTHQ SRFYLSKKKW VMVPMMSLHH LTIPYFRDEE LSCTVVELKY TGNASALFIL PDQDKMEEVE AMLLPETLKR WRDSLEFREI GELYLPKFSI SRDYNLNDIL LQLGIEEAFT SKADLSGITG ARNLAVSQVV HKAVLDVFEE GTEASAATAV KITLLSALVE TRTIVRFNRP FLMIIVPTDT QNIFFMSKVT NPKQA (70-423 aa encoded by B C010530)
靶标信息
SERPINA encodes Alpha 1-ACT. It is an early-stage acute-phase plasma protein and a serpin that preferentially inactivates chymotrypsin, cathepsin G, and chymase. Alpha-1-ACT, a serine protease inhibitor, is tightly associated with amyloid plaques in Alzheimer's disease (AD) and in normal aged human and monkey brain. Regulation of the serine proteases and serine protease inhibitors plays an important role in neuromuscular differentiation. Prostate specific antigen (PSA), a chymotrypsin-like serine protease, is predominantly complexed to Alpha-1-ACT.
仅用于科研。不用于诊断过程。未经明确授权不得转售。